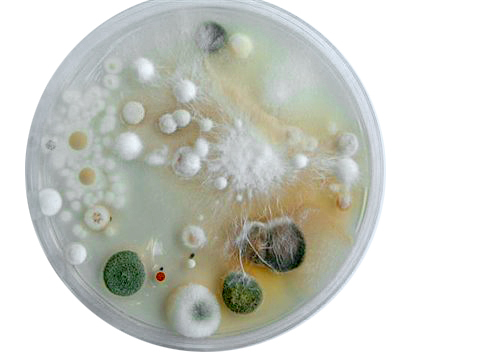
nuimaikinpuk's profile picture. friendly noise

Contemplating pump opportunities to counter the lack of momentum in altcoins. @Trader_B_ @0xRedsnow_y @bovtega1900 @CryptoSurfing0 @tradernoche @Cng7Lm @KruSzekOkruSzeK @SolanaShu @anchor_great @MrBukky_ @LFG_Sasuke @leongrimm_ @FuturAIstic
🚀Today there will be pump at 09:00 GMT 📷t.me/CryptoSignalBy… Take part in this, get ready for the pump now. Profit is guaranteed! 📷 📷Detailed guide for all traders! 📷 ✅✅
NEW: Study on severity of those infected with the #OmicronVariant compared to the #DeltaVariant: ⬇️53% less risk of symptomatic hospitalization ⬇️74% less risk of ICU admission ⬇️91% less risk of death 0⃣Omicron patients required mechanical ventilation bit.ly/3GiRpBC

Just joined the 100 subscribers on YouTube club. VIRTUAL HIGH-FIVE! youtube.com/channel/UCTVxo…
Join Robinhood with my link and we'll both get a free stock join.robinhood.com/suttics-151968
I added a video to a @YouTube playlist youtu.be/B1hhUuxnIfI?a DIY 12s Monster Electric Skateboard Power-sliding and Drag Racing
I added a video to a @YouTube playlist youtu.be/H-av9tBdpxU?a Building a Better Boosted Stealth Electric Longboard
I added a video to a @YouTube playlist youtu.be/H-av9tBdpxU?a Building a Better Boosted Stealth Electric Longboard
United States Trends
- 1. Comey 87.6K posts
- 2. Thanksgiving 161K posts
- 3. Halligan 26.9K posts
- 4. Pentagon 13.6K posts
- 5. Opus 4.5 2,562 posts
- 6. #WooSoxWishList 8,004 posts
- 7. Department of War 19.1K posts
- 8. Mark Kelly 67.7K posts
- 9. Dismissed 42.8K posts
- 10. Jimmy Cliff 31.7K posts
- 11. Max Brosmer 1,029 posts
- 12. Hegseth 22.6K posts
- 13. #NutramentHolidayPromotion N/A
- 14. TOP CALL 5,701 posts
- 15. Department of Defense 3,809 posts
- 16. Ja'Kobi Gillespie N/A
- 17. Tish James 4,132 posts
- 18. AI Alert 3,890 posts
- 19. #stayselcaday 5,634 posts
- 20. Statute 16.1K posts
Something went wrong.
Something went wrong.